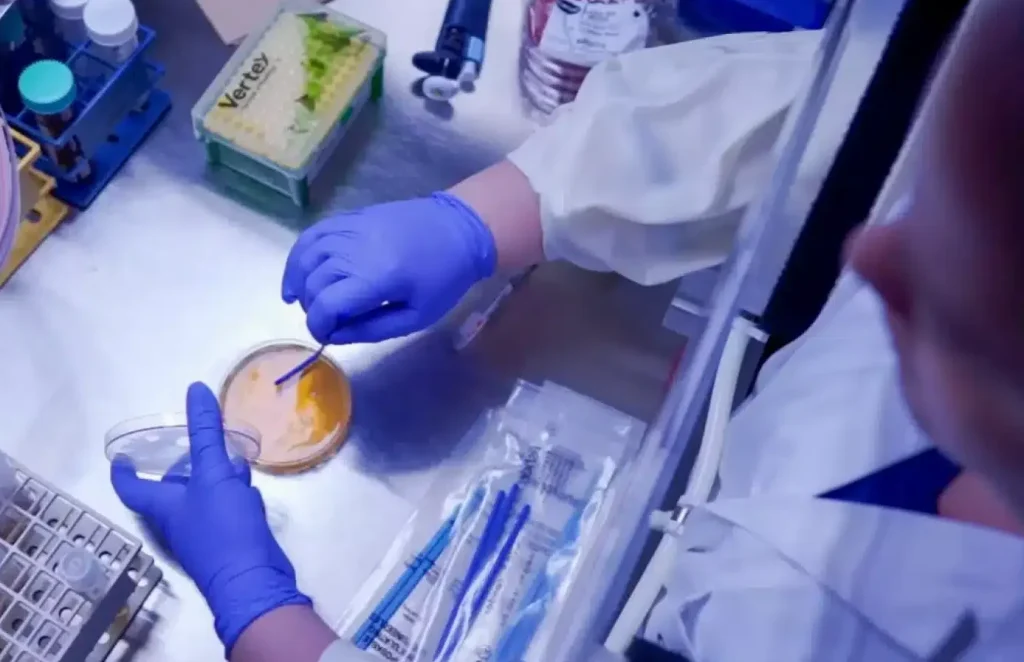

Guy Lafleur, one of history’s greatest hockey players, set up the Guy Lafleur Fund in 2021 following his own battle with cancer. Today, his son and other inspiring ambassadors are mobilizing oncology research at the CHUM.

When filing out the donation form, select Guy Lafleur Fund from the dropdown menu in the designation section.
Defeating cancer through research
The Guy Lafleur Fund finances personalized medicine in oncology—an approach that considers the uniqueness of each person and each tumor to develop more effective and tailored treatments. Thanks to you, research teams have developed promising projects.
Faced with growing needs, the Fund has set an ambitious goal of $10 million to support cancer research. This is a major milestone that reflects the scale of the challenges ahead and our hope for a healthier future for all.
The Personalized Medicine Program in Oncology focuses on the unique characteristics of each cancer to develop tailor-made therapeutic solutions. Rather than targeting the cancer’s location alone, as with chemotherapy, this program considers the specific traits of the cancer and the individual being treated. With your support, clinical and fundamental research teams have made promising strides.
Ambassadors

Martin Lafleur, son of Guy and his partner Angelica Viapiano, a residential and commercial real estate broker with RE/MAX CRYSTAL.

Guy Carbonneau, a professional hockey player, and his partner Line Boivin, a corporate founder and manager.

Dary Laflamme, CEO of Boscus Canada Inc., and his partner Marlène Castonguay, a retired health care professional.
“Cancer has profoundly impacted my family’s life, just as it has for so many others across Quebec. Let’s stop losing the people we love. In honour of my father, I invite you to join me in making his vision a reality.”
— Martin Lafleur, Guy Lafleur Fund Ambassador









